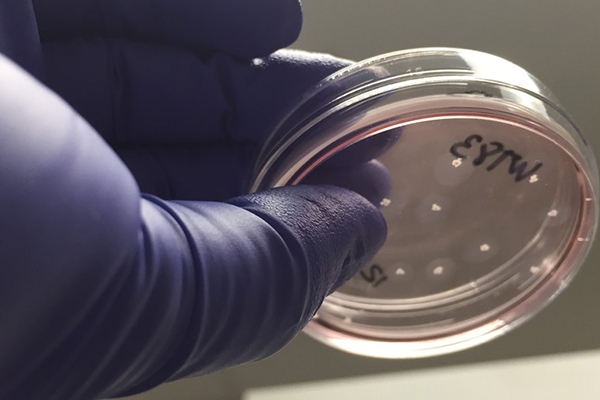
Novo laborat�rio em SP cria 'minic�rebros' para tratamento de autismo.

Um novo laboratório localizado em São Paulo criará “mini-cérebros” para ajudar no tratamento personalizado de pacientes com autismo.
Inaugurado neste sábado (24), a startup de biotecnologia Tismoo é uma parceria entre o biólogo molecular Alysson Muotri, da Universidade da Califórnia, e a professora Patrícia Beltrão Braga, da USP. Eles pretendem, por meio da análise genética dos pacientes, obter um tratamento mais certeiro para a doença.
De acordo com Muotri, o laboratório é o primeiro do tipo no mundo. O passo inicial do tratamento é fazer a análise genética detalhada de cada indivíduo ou família, e detectar a mutação que causou o autismo. Ele defende que a técnica, em alguns casos, seja feita pelo menos com o pai, mãe e filho -- no caso de o casal desejar um segundo filho, isso é importante.
O segundo passo é analisar a mudança nos genes e mapear os tratamentos possíveis. Boa parte das mutações não estão catalogadas, por isso o laboratório irá rastrear na literatura médica tudo o que está em fase de pesquisa.
O último passo é o dos “minicérebros”. Com o mapa genético do paciente em mãos, é feita uma reprogramação celular por meio de células-tronco e são criados esses "minicérebros" com a genética do autista. São pequenas estruturas de neurônios que recriam em certa medida o funcionamento cerebral. Desta forma, é possível testar quantos medicamentos forem necessários para o tratamento.
Mas o "minicérebro" não tem uma estrutura completa e não é um cérebro em miniatura. Ele não tem consciência, mas simula de forma rudimentar o tipo de organização que existe no cérebro humano.
A vantagem de usar "minicérebros" em laboratório é que eles crescem como culturas de células e formam naturalmente uma estrutura em camadas – similar à que existe no córtex, a superfície do cérebro, responsável pelo processamento mais sofisticado de informações no sistema nervoso.
Possuindo tamanho médio em torno de 30 micrômetros — largura de um fio de cabelo de bebê – essas estruturas são maiores que os grupos isolados de neurônios em cultura de células bidimensionais. É possível, assim, medir os impulsos elétricos que trafegam por essa estrutura e verificar se estão ocorrendo de forma normal.
“Você pode criar 100 ou 200 ´minicérebros´, gerados a partir de células-tronco. E com isso pode testar 100 drogas ao mesmo tempo, o que é uma coisa que jamais um médico conseguiria em um ser humano”, explicou Muotri.
Por enquanto, o laboratório deverá focar no tratamento de autismo. Muotri diz que, no futuro, devem expandir para outras síndromes.

Copyright Jornal Cruzeiro do Vale. Todos os direitos reservados. É proibida a reprodução do conteúdo desta página em qualquer meio de comunicação, eletrônico ou impresso, sem autorização escrita do Jornal Cruzeiro do Vale (contato@cruzeirodovale.com.br).